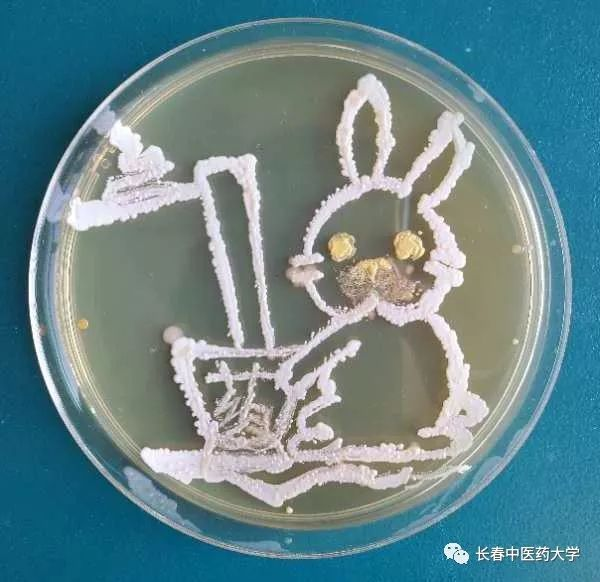

职教体验官-我是“食品检验员”
随着社会经济的不断发展,人们生活水平和保健意识在不断提高,人们越来越注重提高食品质量、减少食物中有害物质残留的有关方法。食品检验员就是这样一类人,他们承担起了保障食品的质量与安全重要任务,完善了食品的安全检测体系,加强食品安全检测技术水平,与食品生产者共同为消费者撑起一片食品安全的天空。
图1 美食
今年的职教周活动,BV伟德官方网站食品公司为同学们提供了一个特殊的平台和机会,开展了一场职教体验官-我是“食品检验员”活动,同学们跃跃欲试,在职业体验中受益颇丰。
食品检验员是指研究和评定食品质量及其变化的一门学科,它依据一些物理、化学、生物化学的基本理论和各种技术,按照国际、国家食品卫生、安全标准等规定,对食品原料、辅助材料、半成品、成品及副产品进行质量检查,确保其质量合格。
实际上,食品检查员就是负责食品检验的人。对食品进行感官检测、理化检验、检查微生物是否超标,对于食品检验员来说可都是小case了!各种食品的微生物检测、分析仪器的使用可都是信手拈来了!
首先,让我们穿上实验服,开始今日的检测之旅。
快来猜猜我们在做什么?
图2 样品的采集与处理
食品检验的操作基础有样品的采集与前处理、食品检测技术的方法选择组成。这是对于待检样品的采集与前处理。从原料或产品的总体中抽取样品,去掉试验样品中不值得分析的部分和一部分杂质,保证分析试样十分均匀。之后开始项目检测,这个过程可不一般哦,感官评价、化学分析、仪器使用、理化检测、微生物检验等等,这都是食品检验检测员的日常哦,有木有被惊讶到!!!
图3 食品感官评价
对于所有食品来说,感官评价必不可少,这是食品检测的第一关,所有感官评价不合格的产品,直接被打上了“不合格品”的标签,那样就不需要检测其他项目了。感官评价过关,看进行理化检测,这个过程检测项目很多,如蛋白测定、水分测定、酸度测定、食品添加剂的测定等等,当然还要用到很多高端仪器。

图4 蛋白质的测定

图5 酸度测定

图6 水分的测定

图7 脂肪含量的测定
你能看出来我们在做什么吗?
(偷偷告诉你哦,这是火腿肠中亚硝酸盐的测定。有木有搓搓双手想试试??)
图8 亚硝酸盐的测定
看看这些仪器你认识吗?这其实也是食品检验检测员工作的一部分哦——仪器分析,是不是觉得很高大上!!!以下分别是自动电位滴定仪、组分测定仪、农残检测仪,有木有很专业!

图9自动电位滴定仪

图10组分测定仪

图11 农残检测仪
说起食品安全检测,就必须要提微生物检测了,食源性病原微生物引起的食源性疾病是食品安全的核心问题,食源性病原微生物可通过接触表面、水、土壤、空气、排泄物、食物等媒介传播,从而污染“从农田到餐桌”的食物链任何环节。
所以,为确保食品安全,微生物检测环节显得尤为重要。
图12 微生物检测之镜检
图13 微生物检测之菌落计数
哇塞!看到这些是不是感觉很奇妙!
看我们食品检验检测员也是艺术家,用微生物“画画”! 建造你未曾见过的美丽小世界!!!

图14 微生物检测之培养
情定食品业,争做中国食品人!
食品检验检测员做一名服务于食品的高素质“硬核”人才,为老百姓舌尖上的安全营养保驾护航。
有木有觉着责任感爆棚,邀您共筑食品梦,不辞长作食品人!